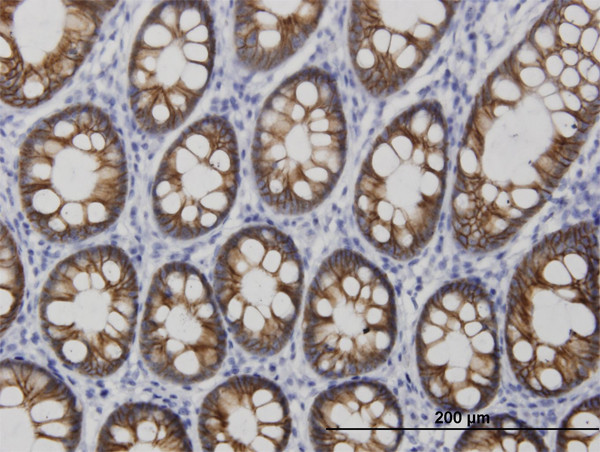
CDH17 Antibody in Immunohistochemistry (Paraffin) (IHC (P))

Search
Abnova
CDH17 Monoclonal Antibody (3H2)
{{$productOrderCtrl.translations['antibody.pdp.commerceCard.promotion.promotions']}}
{{$productOrderCtrl.translations['antibody.pdp.commerceCard.promotion.viewpromo']}}
{{$productOrderCtrl.translations['antibody.pdp.commerceCard.promotion.promocode']}}: {{promo.promoCode}} {{promo.promoTitle}} {{promo.promoDescription}}. {{$productOrderCtrl.translations['antibody.pdp.commerceCard.promotion.learnmore']}}
产品信息
H00001015-M03
种属反应
宿主/亚型
分类
类型
克隆号
抗原
偶联物
形式
浓度
规格
纯化类型
保存液
内含物
保存条件
运输条件
产品详细信息
Sequence of this protein is as follows: EGKFSGPLKP MTFSIYEGQE PSQIIFQFKA NPPAVTFELT GETDNIFVIE REGLLYYNRA LDRETRSTHN LQVAALDANG IIVEGPVPIT IEVKDINDNR PTFLQSKY
靶标信息
CDH17 gene is a member of the cadherin superfamily, genes encoding calcium-dependent, membrane-associated glycoproteins. The encoded protein is cadherin-like, consisting of an extracellular region, containing 7 cadherin domains, and a transmembrane region but lacking the conserved cytoplasmic domain. The protein is a component of the gastrointestinal tract and pancreatic ducts, acting as an intestinal proton-dependent peptide transporter in the first step in oral absorption of many medically important peptide-based drugs. The protein may also play a role in the morphological organization of liver and intestine. Alternative splicing results in multiple transcript variants.
仅用于科研。不用于诊断过程。未经明确授权不得转售。
篇参考文献 (0)
生物信息学
蛋白别名: Cadherin; cadherin 17, LI cadherin (liver-intestine); cadherin-16; Cadherin-17; FLJ26931; HPT-1 cadherin; human intestinal peptide-associated transporter HPT-1; human peptide transporter 1; Intestinal peptide-associated transporter HPT-1; LI cadherin; LI-cadherin; Liver-intestine cadherin; MGC138218; MGC142024; unnamed protein product
基因别名: CDH16; CDH17; HPT-1; HPT1
UniProt ID: (Human) Q12864
Entrez Gene ID: (Human) 1015